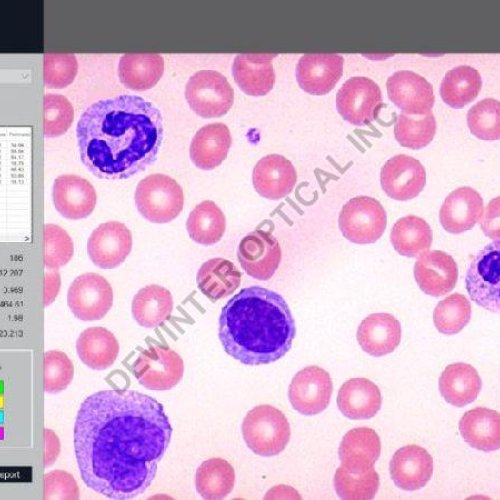
Biowizard Live Biological Microscope measurement Software

View Mobile Number
admin@dewinterindia.com
| Business Type | Manufacturer, Exporter, Supplier, Retailer |
| Brand Name | Dewinter |
| View | Zoom in/Zoom out, rotation 90°,180°,27°, horizontal flip/vertical flip, Redo/Undo, Intensity histogr |
| Image Processing | Background subtraction, contrast enhancement, boolean math, ADD,OR,XOR etc. |
| Click to view more | |
Product Details
Routine Filters
Invert, Brightness, Contrast, Hue, Saturation, Blur. Noise removal, Gamma RGB, etc.
Edge Detection & Morphology Function
Lap-lacing, sobel, Kirsh, Skelotizing, pruning, histograme equalization, histogram smoothing etc.
Looking for "Biowizard Live Biological Microscope measurement Software" ?
piece
Explore More Products












